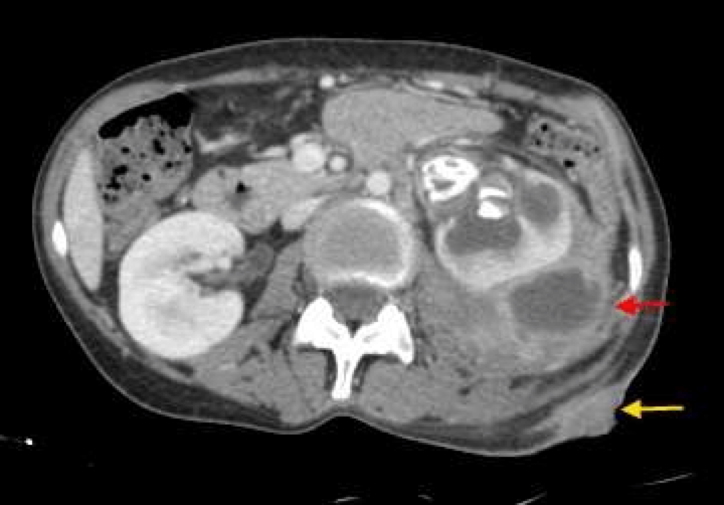
RENAL AND PERINEPHRIC ABSCESS

Table of Contents
Overview – Renal and Perinephric Abscesses
Renal and perinephric abscesses are serious complications of urinary tract infections, most commonly developing following unresolved or severe pyelonephritis. Caused most frequently by Escherichia coli, these abscesses can occur within the renal parenchyma or the perinephric space surrounding the kidney. Clinical presentation may mimic pyelonephritis but tends to be more severe and persistent, and often requires imaging for diagnosis. Prompt drainage and targeted antibiotic therapy are essential to prevent progression to sepsis or long-term renal damage.
Definition
A renal abscess is a collection of pus within the kidney tissue, whereas a perinephric abscess involves the space around the kidney. Both are complications of upper urinary tract infections and require urgent medical attention.
Aetiology
- Usually a complication of pyelonephritis
- Most commonly caused by E. coli
- Less commonly due to other Gram-negative or Gram-positive organisms
- May be secondary to:
- Obstructive uropathy (e.g. staghorn calculi)
- Incomplete resolution of infection
- Haematogenous spread in immunocompromised patients
Clinical Features
- Similar to severe pyelonephritis
- Fever
- Flank or abdominal pain
- Dysuria, urinary frequency
- May be unilateral or bilateral
- Palpable mass may or may not be present
- Perinephric abscess may show inflammatory changes of the overlying skin (e.g., erythema, warmth, tenderness)
Investigations
- Urine analysis:
- Pyuria, haematuria, bacteriuria
- Urine culture and sensitivity:
- Guides antibiotic therapy
- Imaging is essential:
- CT abdomen – gold standard for diagnosis and localisation
- Ultrasound (USS) – may detect larger fluid collections
Management
Antibiotic Therapy
- Empirical coverage initially; tailored based on culture results
- Trimethoprim–sulfamethoxazole is a common choice
- Broader spectrum options if resistant organisms suspected
Drainage
- Percutaneous fine needle aspiration (FNA) or drainage under radiological guidance
- Surgical drainage in cases where percutaneous methods fail or are contraindicated
Address Underlying Causes
- Investigate and treat contributing factors:
- Staghorn calculi, urinary obstruction, indwelling catheters, diabetes
Complications
- Urosepsis
- Renal failure
- Chronic kidney disease (if significant renal parenchymal destruction)
- Recurrent infections if underlying cause is not corrected
Differential Diagnosis
- Pyelonephritis
- Perinephric haematoma
- Renal cell carcinoma
- Hydronephrosis due to obstructive uropathy
- Appendicitis or diverticulitis (for lower quadrant abdominal pain)
Summary – Renal and Perinephric Abscesses
Renal and perinephric abscesses are serious complications of pyelonephritis, most commonly caused by E. coli. These infections often mimic but exceed the severity of typical pyelonephritis and require imaging for diagnosis. Management includes drainage, antibiotic therapy (such as trimethoprim–sulfamethoxazole), and addressing any underlying causes such as obstruction or stones. For a broader context, see our Renal Overview page.